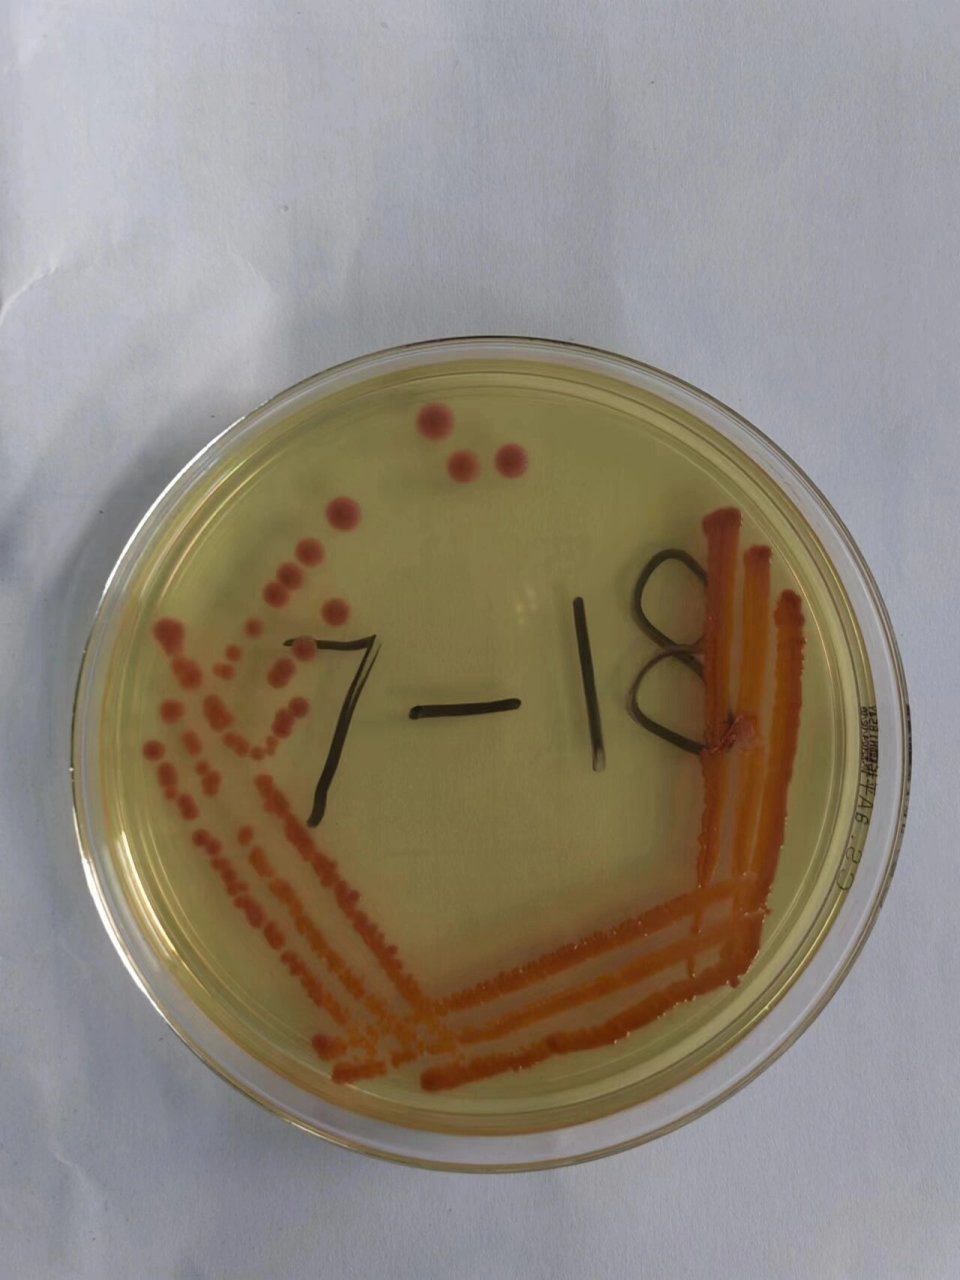
实验课之细菌平板划线分离培养法 周一做的实验,好玩的捏,第一区划得
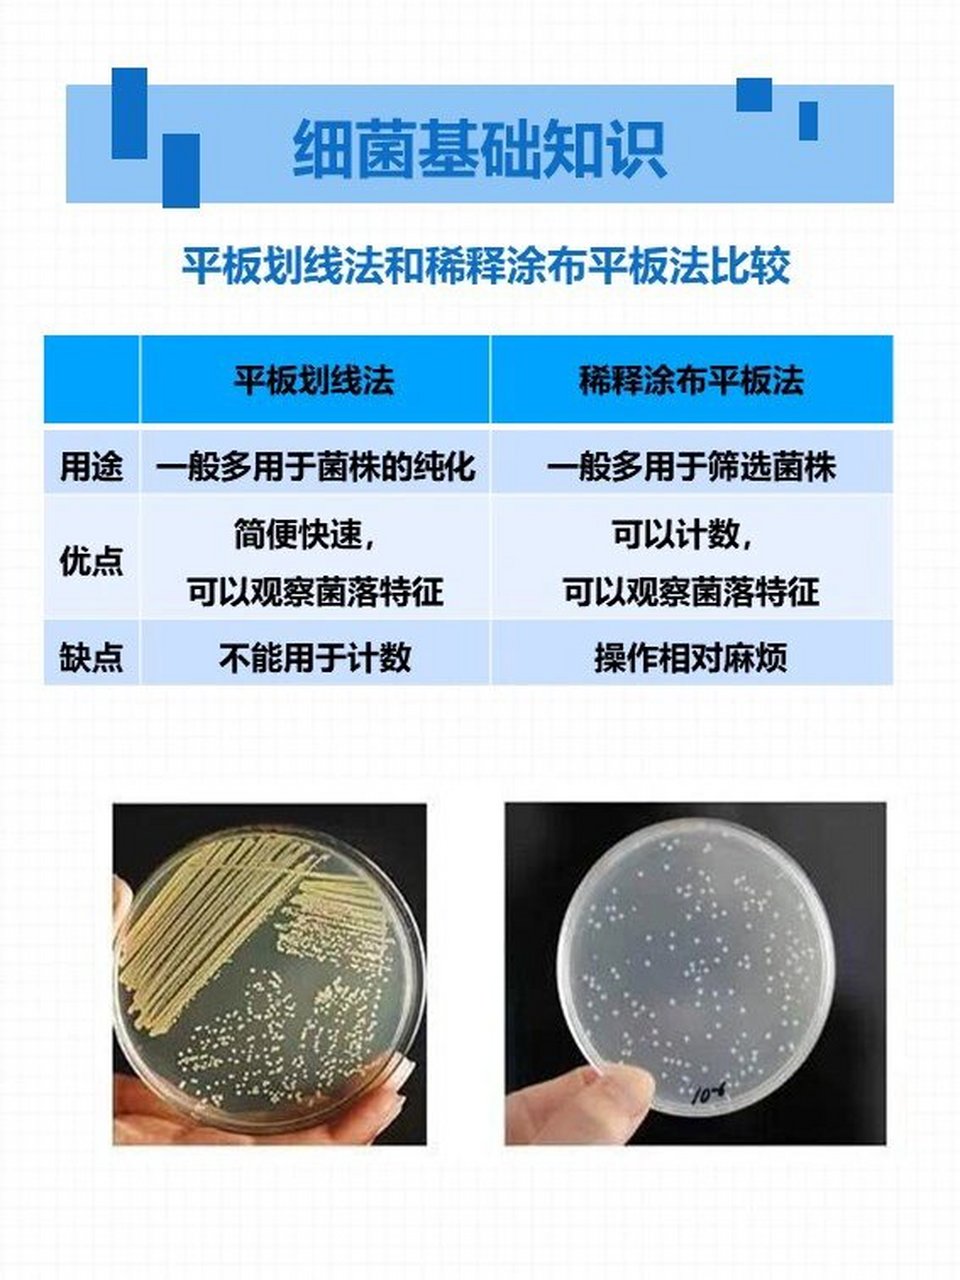
👿细菌基础知识|两种细菌分离方法比较 1⃣️平板划线法和稀释

平板划线法生长现象

平板划线分离法常见问题.平板划线分离法常见问题 1培养基灭菌 - 抖音
图片尺寸450x339
平板分区划线四区
图片尺寸960x1280
分析平板划线法分离微生物失败的原因 大家好,我是化验小姐姐,从事于
图片尺寸1440x1920
平板划线操作流程-微生物化验员证报名培训.平板划线操作流程- - 抖音
图片尺寸971x671
平板划线
图片尺寸1920x2560
平板划线法得到单菌落 同学做一次就成功,而我没分离开,我的板都是
图片尺寸1280x1706
平板划线
图片尺寸1920x2560
平板划线 三区平板划线的详细操作来啦 附上小金之前划线的简单
图片尺寸1200x1600
63高中生物一轮复习资料 无菌技术 微生物纯培养 平板划线法
图片尺寸1721x3805
平板划线分离法
图片尺寸1395x802
实验课之细菌平板划线分离培养法 周一做的实验,好玩的捏,第一区划得
图片尺寸960x1280
平板划线 三区平板划线的详细操作来啦 附上小金之前划线的简单
图片尺寸1200x1600
平板划线接种法(葡萄球菌/大肠杆菌) 2.
图片尺寸1920x1920
👿细菌基础知识|两种细菌分离方法比较 1⃣️平板划线法和稀释
图片尺寸960x1280
平板划线操作
图片尺寸960x720
培养基制备,平板划线的注意事项!
图片尺寸660x306
高中生物实验课 | 稀释涂布平板法 | 微生物
图片尺寸1920x2560
平板划线 三区平板划线的详细操作来啦 附上小金之前划线的简单
图片尺寸1200x1600
平板划线接种法(葡萄球菌/大肠杆菌) 2.
图片尺寸1920x1920
平板划线示例
图片尺寸244x237